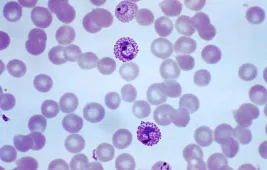

Статьи о микроскопах, микропрепаратах и исследованиях микромира
Перед покупкой микроскопа следует задуматься не только о том, как правильно его выбрать, но и как работать с этим оптическим прибором, как готовить микропрепараты, как ухаживать за оптикой. Статьи о микроскопах, микропрепаратах и исследовании микромира – отличная возможность расширить свои знания и начать лучше ориентировать в микроскопии.
Предлагаем вашему вниманию полезные и интересные материалы, подготовленные сотрудниками нашего интернет-магазина.